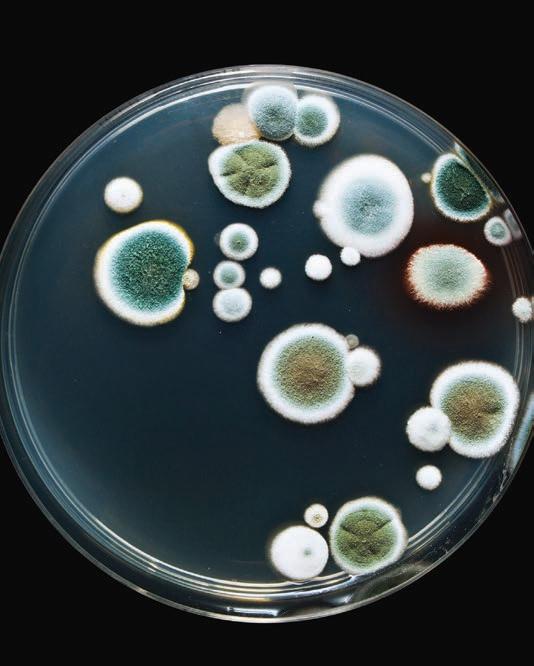

38th Annual Mushroom Festival 2023 & Visitors Guide
























































 By Chris Barber Contributing Writer
By Chris Barber Contributing Writer

The continuing popularity of Kennett Square’s annual Mushroom Festival likely lies in the innovations and adaptations by its leaders -- this year those leaders are executive director Gina Puoci and Festival Coordinator Gale Ferrante. What started out as a simple, one-day celebration on State Street in 1986 that attracted a modest crowd of onlookers has turned into a nationally recognized celebration of the locally grown crop. Now, the festival is spread out over two funfilled days and draws tens of thousands of visitors on each day.
Continued on Page 8










Continued from Page 6
When longtime chairman Kathi Lafferty retired from her position after the 2019 event, Kennett Fire Company administrator Puoci and mushroom company co-owner Ferrante took the reins. They faced significant challenges as the fair had been cancelled due to the pandemic in 2020 and was greatly diminished in 2021 with a change of location to the parking lot of the former Genesis building across from Kennett High School.

Nonetheless, they proceeded in that 2021 comeback year with vendors, kids rides, demonstrations, entertainment and even the eating contest in that limited courtyard.
When the full-blown version of the festival came back in 2022, they moved back uptown and brought the return of a wide variety of vendors, the car show, souvenirs, the painted mushrooms and all the excitement people fill the street for.
The 2023 festival, as is tradition, will take place uptown in the borough on the weekend after Labor Day, this year on Sept. 9 and 10. Geographically, it will run on State Street at Church Alley on the east to Garfield Street on the west (Church Alley is the narrow road that runs between the former library and the rear of the American Legion.).
The antique car show will run the length of South Broad Street and another stage will be added on South Union Street for culinary events.

Continued on Page 11













Continued from Page 8
Puoci said the festival’s duration will be shortened by one hour from last year on both Saturday and Sunday, running the event from 10 a.m. to 6 p.m. on Saturday and 10 a.m. to 4 p.m. on Sunday, giving the crew more time to clean up. Admission is $5 this year.
Through the years, some features have come and gone, like the Miss-America-like queen pageant, the Friday night parade, the three-night carnival downtown, the Ferris Wheel and the art show. But this popular annual festival has survived hurricanes, blistering heat, rainstorms and the devastating COVID-19 pandemic. Through it all, the fair has almost always attracted visitors from far away – not just Philadelphia and Delaware County. It was reported that some even arrived from European countries because they heard so many good reports about the festival.
This year, the big news is that the mushroom-picking contest, which took place for several years more than a decade ago, is returning. This event in the past has elicited a great deal of

enthusiasm, especially among the harvesters in the respective companies. This year the contest will take place on South Broad Street and will pit three teams of two pickers each against each other both
Continued on Page 12

Residents have the comfort of knowing that they can receive personal care without having to move. Care is brought to them. Quality of life, combined with a comfortable setting, makes Friends Home unique. It is the residents who fill the community with their vitality and spirit that make this a very special place, indeed.



Continued from Page 11
days. There will be a winning team each day. “I’m really excited about that. It has a lot of support. The winners will get something and everyone else will get something [as well],” Ferrante said.

The winners will be judged on speed, quality and size of the mushrooms picked. The potential competitors are invited to submit a request to participate ahead of time and will be chosen by random lottery.

Ferrante, who speaks fondly of the support the Mushroom Festival gives to the surrounding community in the form of donations, said the inclusiveness of this contest will widen the scope of the people it includes.


Also on South Broad Street is the large growing tent where visitors can see and even touch the trays and contents where mushrooms actually grow. Mushroom growers are there to answer questions.
Additionally, in a related new event, the American Legion building will be open for showings of a continuously running video of the whole growing process of mushrooms. This replaces and significantly simplifies the past practice of offering bus rides to tours of nearby mushroom farms to see the operations onsite.
One block to the west of the Broad Street events, South Union Street, the area that borders on the Fragale Barber Shop and former Senior book store, will house a new stage that offers culinary events.
The cooking contest will be there in the form of two “chopper” contests in which adults in one and youth in the other are given a pre-selected quantity of food, and

they must make it into a delicious entree.
South Union Street also is the site of a lecture by Kiki Aranita, who formerly owned Poi Diog restaurant in Philadelphia. The ever-popular and exciting mushroom eating contest will be back again at 12:30 p.m.
Attendees at recent Mushroom Festivals may have fond memories of the Sunday afternoon soup and wine event. This is another event that has yielded to newer features. There will be no lack of food, however.
Visitors will have no problem satisfying their hunger and interest in cooking—there will be plenty of vendors, contests and lectures about mushrooms.


As of mid-July, Puoci said almost 200 vendors, including local restaurants, had already signed up to place their booths along the street. Many will be selling craft and souvenir products, but others will offer everything from ice cream to mushroom specialties. There will also be soup for sale on South Broad Street.

Many familiar events will also be back such as Cute as a Button photos of kids, souvenir T-shirts and painted mushrooms. Kids’ rides will take place at the west end of State Street.
After a long run of having visitors park at the parking lot at Exelon in Kennett Township, that venue became unavailable in 2020. The Chatham Financial parking lot on McFarlan Road served the purpose well last year, Puoci said, and that will be the location this year as well as Kennett High School. Bus transportation will be provided throughout the festival to shuttle visitors to the event.
More information about the festival, including an updated schedule of events, is available online at Mushroomfestival.org.

 Crowds arrive early and in great quantity every year at this engaging event.
Crowds arrive early and in great quantity every year at this engaging event.
Let’s begin in the early 1900s with a young man named Raymond Rettew. Born in West Chester, he attended the University of Delaware and Swarthmore College, graduating with a degree in chemistry. In March 1926, after working in his father’s law office, Rettew accepted a position as a chemist at the Charles E. Hires Company in Philadelphia, Pennsylvania.
While Rettew’s primary work was in microbiological control, the company allowed him enough time to take an advanced bacteriological course at the University of Pennsylvania, and the professor allowed Rettew to use the laboratory during late hours and on weekends to conduct studies and help Rettew start his own business.
In his own words from his memoir, “A Quiet Man from West Chester,” Rettew talked about this time in his life. “My father-in-law, Mr. Wilmer J. Divine, was employed in the cultivated mushroom industry. In my talk with him, it became evident that the business needed scientific study and scientific help. During my off-hours I did research in the production of mushroom spawn and in pH studies of casing soil and compost. My brother-in-law, Floyd W. Divine, who was also in the mushroom growing field, tested the results in the mushroom houses.”
In the meantime, another factor was developing in Rettew’s life. While commuting to the Hires Company, he rode on the train from West Chester every day with Joseph W. Strode. On their commutes, they would talk about a variety of things, including Rettew’s interest in the challenges faced by the mushroom industry. One morning, Strode made Rettew an offer: “When you are ready to go into the mushroom spawn business, let me know.” As Rettew explained in his memoir, “That very evening, I went to see him and for many years to come, we were partners.”
In 1929, the two started production at the Chester County Mushroom Laboratories, in West Chester, Pennsylvania. Strode supplied the money and Rettew supplied the knowhow. The idea was to supply mushroom growers with the highest quality spawn produced by scientific methods and conduct original research for applying spawn. In three years, the lab was the largest spawn maker in the United States.
In 1931, a subsidiary corporation was established, The Premier Mushroom Company. Rettew visited Clarence Birdseye—yes, that Birdseye—concerning freezing mushrooms. Birdseye was pioneering freezing vegetables, so Premiere entered into a contract with Birdseye, and after some successful tests with freezing mushrooms, Premiere became one of the first companies to package and sell frozen foods.
In the decade that followed, Rettew’s company enjoyed many successes; spawn sales increased here in the United States and overseas, he was awarded a few patents for use in his research, and more. Things were going very well.
But World War II changed Rettew’s approach to business. He encouraged the industry to study the food value of mushrooms so they could be declared an essential food. Rettew also tapped into his hobby studying chemical substances produced by fungi to see if he could be of any help in the war effort. He was a self-described ‘tinkerer’ and had been working on the extraction of the enzyme tyrosinase from mushrooms. The extraction was successful, but the medical use was questionable.
A few years before, Alexander Fleming observed the growth pattern of mold on a staphylococcus culture plate. Specifically, he saw that if penicillium, a genus of fungi, was grown in the appropriate substrate, it would produce an antibiotic substance, which he called penicillin. Fleming
Continued on Page 16
Chester County has a rich history, but there’s probabl in Chester County, about a breakthrough discovery,

bly one story that you haven’t heard that happened here, a world war, and of course, mushrooms.
MICHAEL R. PERNA, Esquire
JENNIFER ABRACHT, Esquire
RYAN G. BORCHIK, Esquire
OLIVIA J. ISSERTELL, Esquire
Maggie Cannon, Paralegal
Beatriz Merino, Bilingual Paralegal with concentration in :
PERSONAL INJURY LITIGATION
CRIMINAL DEFENSE
DOMESTIC MATTERS
AUTO ACCIDENTS
WILLS AND ESTATES
REAL ESTATE TRANSACTIONS
EMPLOYMENT MATTERS
COMMERCIAL MATTERS
TEL/ 610-444-0933
FAX / 610-444-5695
PA@PA4LAW.COM

610 MILLERS HILL - P. O. BOX 96
KENNETT SQUARE, PA 19348
SE HABLA ESPAÑOL
Continued from Page 14
later deduced that penicillin could be used as an antibiotic to treat life-threatening illnesses including meningitis, pneumonia, syphilis and other forms of bacteria.
It wouldn’t be until more than 10 years later that it was discovered penicillin was in fact, a ‘miracle cure.’ On May 14, 1942, the first American patient was treated with penicillin. The patient was a woman named Anne Miller. The diagnosis was septicemia, also known as blood poisoning, that had left her near death from an infection that followed a miscarriage. She had had a fever of at least 103°F for multiple weeks. She received roughly a tablespoon of penicillin, and within about a day, her temperature was back to normal.
Back in Chester County, Rettew was researching ways to help. He was familiar with the work of Dr. Harold Raistrick of the University of London, who pioneered research on the chemical composition of fungi. He had also studied penicillin, and in 1941, Rettew read papers and articles
Continued on Page 18

Continued from Page 16
that indicated penicillin had great promise for healing infected wounds. He was also aware of the news that the men fighting in WW II were dying at high rates from infections and amputations.
So Rettew went to work.
Having studied penicillin intermittently since 1928, Rettew knew that by altering the culture, or medium in which the mycelium grew, he could improve the quality of the spawn. He figured the same process would apply to penicillin growth. “This,” he wrote in his memoirs, “would be our way of contributing to the War effort.”
The original work was done in Rettew’s private laboratory above the garage of his home. There, he proved that the experience of extracting chemical substances from fungi, together with the techniques used for the culture of mushroom spawn, made a good starting point for the study of penicillin.

Rettew had found a way to commercially produce penicillin. This was a significant discovery, as previous attempts by researchers to make penicillin


Continued from Page 18
widely available was “difficult and expensive to extract” from its original mold source. Before Rettew, it had not been available in synthetic forms; every time scientists wanted to make penicillin, they had to wait for new mold to grow. So, he put his idea into action.

Through his friend Dr. E.B. Lambert, he contacted the Chairman of the Committee on Medical Research of the Office of Scientific Research and Development located in the National Academy Building in Washington, D.C. The building is of note because it’s the same building where the control center was housed for the atomic bomb. It was there that Rettew convinced the leaders that the Chester County Mushroom Laboratories could contribute to the penicillin program, which the Federal Government had just established as a priority.
Continued on Page 22








Continued from Page 20
Funded by the federal government and John Wyeth and Brother Incorporated, a subsidiary of the American Home Products Corporation, Rettew went to work with penicillin samples provided by the Department of Agriculture’s Northern Regional Research Laboratory at Peoria, Illinois. Using his own lab’s UV lights and temperature control mechanisms to meticulously sterilize the medium bottles, Rettew was soon able to produce five-gallon drums of penicillin–but there was a problem. “Since penicillin was not particularly stable,” Rettew later wrote, “degradation was often faster than separation of the liquids.” The solution, it turned out, was to use a centrifuge manufactured by the Sharpless Cream Separator Company of West Chester to separate the penicillin from the growth medium. “Penicillin production today would not be possible without this method,” Rettew later

Continued on Page 24




Continued from Page 22
noted. He then constructed a penicillin recovery building equipped with a large refrigerator, Sharpless centrifuge, and a 100-gallon tank.
By June 1943, Rettew’s Chester County Mushroom Laboratories were the nation’s most consistent source of commercially available penicillin, more than ninety percent of which went directly to the armed forces. By the fall of 1943, an expanded lab in West Chester, utilizing Rettew’s surface culture technique, was producing most of the world’s penicillin.
History books point to Alexander Fleming for discovering penicillin, and he and his colleagues were awarded the Nobel Prize in Physiology or Medicine for their discovery in 1945. Rightfully so.
But there is more to the story. Rettew was a self-described quiet man, happier with his research and experiments than standing in the spotlight. You’re hard-pressed to find mention of Rettew in the history of penicillin; a quick Google search

offers only the slightest nod buried deep in a Wikipedia page: “The private sector and the United States Department of Agriculture located and produced new strains and developed mass production techniques.” Those ‘mass production techniques’ helped to save countless lives on the battlefield and even more throughout the years that followed. The ‘Quiet Man from West Chester’ may have shied away from the spotlight, but his discovery changed the world.

Decades later, his family is trying to not only keep his story alive and increase awareness of Rettew’s impact through a documentary titled, The Mushroom Man Who Changed the World: G. Raymond Rettew. Recently premiered at the Chester County History Center, the documentary tells the story of a man who took his work producing spawn for the mushroom industry and turned it into a groundbreaking discovery.
American Mushroom, headquartered in Avondale, is a national voluntary trade association representing the growers, processors, and marketers of cultivated mushrooms across the United States and industry suppliers worldwide. For more information, visit www.americanmushroom.org.

$20 OFF
OF $100 REGULAR PRICE IN STORE PURCHASE (not valid on deliveries, feed, bedding)











When Jackie Gleason’s Ralph Kramden would chafe ‘To the Moon, Alice,’ at his wife played by Audrey Meadows on “The Honeymooners”, he wasn’t talking about mushrooms, but nearly 70 years later, NASA’s Ames Research Center has embarked on the Myco-Architecture Project, which is prototyping technologies that could ‘grow’ habitats on the moon, Mars, and beyond out of mushrooms, and specifically mycelium.
What makes mycelium so attractive to NASA researchers is its ability to be used “dry, wet, frozen with water or as part of a self-produced composite which would allow such enhancements as radiation protection and a vapor seal.”
The interest in mushroom mycelium is not new. In 2014, Ames Research Center students designed a drone made from mycelium. With the guidance and materials from Evocative Design, a custom drone-shaped skeleton was grown. The benefits of a biodegradable Unmanned Aerial Vehicles (UAV) goes beyond the combat zone, but to monitor environmentally sensitive areas and other scientific purposes. If the drone goes down, the organic material is environmentally-safe and friendly. While the drone was not 100 percent mycelium or biodegradable (it still used a traditional rotor, battery, and controls), scientists continue to work to adopt a 100 percent UAV.
Sure, the idea of using mushrooms in space, is well, out of this world. But mushroom mycelium offers a lot of advantages. Right now, humans heading into space are like turtles: they carry their own habitat with them. Sure, it’s efficient, but it takes up a lot of energy. So, what if you could build habitats on the moon?
According to the NASA website, “On Earth, a flexible plastic shell produced to the final habitat dimensions would be seeded with mycelia and dried feedstock and the outside sterilized. At destination, the shell could be configured to its final inner dimensions with struts. The mycelial and feedstock material would be moistened with Martian or terrestrial water depending on mass trade-offs, and heated, initiating fungal (and living feedstock) growth. Mycelial growth will cease when feedstock is consumed, heat withdrawn or the mycelia heat killed. If additions or repairs to the structures are needed, water, heat and feedstock can be added to reactivate growth of the dormant fungi.”
The project is in its infancy, so, as they say, there’s more on the horizon.
And while NASA researchers are looking at what mushrooms can do in space, a little closer to home, computer scientists are trying to see if mushrooms can carry computing and sensing functions; in other words, can mushrooms be an element of a computer motherboard?




Continued from Page 26
Researchers in England believe computers of the coming century will be made of chemical or living systems—or wetware—to work in harmony with hardware and software.
Not surprising, what makes mushrooms so appealing in these studies is the mycelium. The research shows that mycelium acts as conductors as well as the electronic components of a computer; mycelium can receive and send electric signals, as well as retain memory.


That makes sense, sort of.
Mushrooms stay connected with the environment and the organisms around them using a kind of “internet” communication. Some refer to this as the ‘wood wide web.’ And some researchers believe that by deciphering the language fungi use to send signals through this biological network, scientists might be able to not only get insights about the state of underground ecosystems, and also tap into them to improve our own information systems.
Mushroom computers could offer some benefits over conventional computers. Although they can’t ever match the speeds of today’s modern machines, they could be more fault tolerant (they can self-regenerate), reconfigurable (they naturally grow and evolve), and consume very little energy.
Continued on Page 30

Continued from Page 28
Researchers explain it this way: the classical computers today see problems as binaries: the ones and zeros that represent the traditional approach these devices use. However, most dynamics in the real world cannot always be captured through that system. This is the reason why researchers are working on technologies like quantum computers (which could better simulate molecules) and living brain cell-based chips (which could better mimic neural networks), because they can represent and process information in different ways, utilizing a series of complex, multi-dimensional functions, and provide more precise calculations for certain problems.


We don’t have to cue the mushroom robots just yet. For now, all of this is just exciting and interesting research. One day, who knows…maybe we’ll use our mushroom computer to book a trip to the moon on a mycelium drone.
American Mushroom, headquartered in Avondale, is a national voluntary trade association representing the growers, processors, and marketers of cultivated mushrooms across the United States and industry suppliers worldwide. For more information, visit www.americanmushroom.org.





Unlike other fresh food, mycelium provides an afterlife for mushrooms, and it’s showing up outside the produce aisle.
Something’s brewing beneath the surface. The network of branches and the threadlike vegetable part of the mushroom known as mycelium is giving way to a rising new sustainable material. It boasts a plethora of attractive attributes and in the quest for green alternatives, emerging trends, and potentially the next big thing, apparel, home decor, packaging, and biofabrication industries are just a few of those taking note and jumping on the bandwagon.
Like the mushroom itself, mycelium’s vast, dense network of fibers can easily be manufactured, manipulated, and quickly reproduced; it is biodegradable, yet super strong and durable, water and mold-resistant and 100% organic. Mycelium is self-binding and flame resistant, eliminating the need for toxic glues and flame-retardant chemicals. Created without petrochemicals, mycelium materials are completely compostable. Relative to its weight, it is also stronger pound for pound than concrete. Expert mycologists tout mushrooms and its mycelium underbelly as possibly the best thing we can do to save the environment.
Mycologist Phillip Ross began experimenting with fungi and mycelium nearly 25 years ago. What started simply with an interest in growing mushrooms, he soon learned their growing tendencies and wanted to work with them as an art material. He introduced mushroom tissue into molds filled with pasteurized sawdust and allowed the fungus to digest the material. With the material he tested out lounge chairs and side tables; and in 2009, a tipping-point moment; at a contemporary art museum in Düsseldorf, Germany, Ross built a small teahouse from interlocking Reishi mushroom bricks. (He also boiled the bricks into tea for gallery visitors to drink). The bricks were so strong, many of Ross’ woodworking tools broke. It was then, Ross saw the potential of mycelium. As he began to refine his process, others approached him about growing the material for industrial use. Ross has since co-founded MycoWorks, a company dedicated to “mycotecture,” custom-engineered material, completely animal-free.
HIs early studies took place during the pre-internet days. He leaned on trial and error, clubs and books, including those of mycologist Paul Stamets. An author and proponent of medicinal fungi and mycoremediation, in 2005 Stamets published Mycelium Running: How Mushrooms Can Help Save the World. The book serves as a guide to the four areas of “mycorestoration,” breaking down mycelium’s digestive power and how it decomposes toxic wastes and pollutants and more.
This network of roots packs a powerful punch. There are several reasons why a variety of industries are looking at mycelium.
Sustainability: Mycelium is considered an eco-friendly and sustainable material. It can be grown using agricultural waste or other organic substrates, reducing reliance on nonrenewable resources. Additionally, mycelium-based products are biode-

gradable, minimizing environmental impact and waste accumulation.
Versatility: Mycelium offers tremendous versatility in terms of its applications. It can be grown into various shapes, sizes, and textures, making it suitable for a wide range of industries and products.
Rapid Growth: Mycelium exhibits rapid growth rates, sometimes doubling in size within a day. This quick growth allows for efficient production and shorter manufacturing cycles compared to traditional materials, making it an attractive option for industries seeking cost-effective solutions.
Customizability: Mycelium can be easily manipulated during the growth process. By adjusting growth conditions, such as temperature, humidity, and nutrient composition, it is possible to achieve specific material properties and desired characteristics, tailoring the end product to meet industry requirements.
Strength and Durability: Despite its lightweight nature, mycelium possesses impressive structural strength. It can be engineered to enhance its durability and load-bearing capabilities, making it suitable for various applications, including those requiring robust materials.
Health and Safety: Mycelium is generally non-toxic and poses minimal health risks to humans during cultivation and handling. This makes it an appealing choice for industries concerned with occupational health and safety standards.
Innovative Design Possibilities: Mycelium’s unique growth patterns and aesthetic appeal open up opportunities for innovative and visually striking designs. Its organic and natural appearance adds an element of uniqueness to products, appealing to consumers who prioritize sustainability and distinctive aesthetics.
Circular Economy: The use of mycelium aligns with the principles of a circular economy, as it can be integrated into waste management systems. By utilizing agricultural or industrial byproducts as growth substrates, mycelium helps reduce waste and contributes to a more sustainable production cycle.
Mycelium based products are showing up in a variety of areas. Below is a fraction of the mycelium research, experimentation and innovation:
New York-based Ecovative Design developed Mushroom® Packaging in 2007. Made from mycelium and agricultural waste sourced from regional farmers, in a matter of days mushroom products are ready to use. For Ecovative, the ‘why’ behind their innovation is simple --
to grow materials that replace plastics and reduce animal slaughter. Plastics, and specifically single-use plastics are a leading cause of pollution, and according to the company, animal agriculture is the leading cause of global warming.
Bolt Threads, which launched nearly a decade ago, is best known for creating Microsilk, a polymer bioengineered to mimic spider silk. From there, they developed Mylo–a leather-like material made from mycelium. The company has partnered with fashion designer Stella McCartney, which created a handbag for display at the Victoria & Albert Museum in London and Lulu Lemon, that launched the world’s first yoga accessories in 2021.

MycoWorks’ leather-like material is grown through a closed-loop process with a low energy conversion rate that uses minimal water. The biodegradable material can be grown in nearly any size or texture, unlike conventional leather sourced from animal hides. MycoWorks’ material is also water resistant, and it comes in a variety of finishes. The company is producing sheet stock of the material and is working with designers and manufacturers to prototype products and application. Jae Rhim Lee is a South Korean artist whose work encompasses art, science, and culture. An MIT graduate, she studied mycoremediation and visited a green cemetery, which eventually to the idea that fashion, in addition to mushrooms, could be a vehicle for re-imagining one’s relationship with death. She conceptualized
Continued on Page 34

Continued from Page 33
the Infinity Mushroom Suit, a self-recycling organic cotton suit infused with a bio mix of mushroom mycelium and other microorganisms that are supposed to aid in decomposition, work to neutralize toxins found in the body, and transfer nutrients to plant life, so that the remains of the person lost end up helping create new life. The burial suit was thrust into the spotlight earlier this year, when it was announced that 1990s heartthrob Luke Perry, who died suddenly of a stroke, requested to be buried in the Infinity Suit.


Mogu is a company that specializes in mycelium-based materials for interior design and architecture. They offer a range of products, including mycelium-based acoustic panels, wall tiles, and insulation materials. Their solutions provide sustainable and aesthetically pleasing options for building and design projects.

With the goal to make sustainable design both accessible and attractive, biodesigner Danielle Trofe MushLume
Lighting Collection utilizes hemp and mycelium. She grows lampshades that can return safely to the earth, adding nutrients back to the soil rather than pollutants. Available for individual purchase, her designs are also found in workplace, hospitality and retail including a canopy of mushroom lights at 1 Hotel Brooklyn Bridge and Blue Park Kitchen in NYC’s financial district.

Continued from Page 34

bioMASON focuses on sustainable construction materials. They have developed a process that uses mycelium to grow biocement-based products. Their mycelium-based bricks offer an eco-friendly alternative to traditional concrete bricks, reducing carbon emissions and energy consumption in the construction industry.

Researchers at Stanford University have also investigated the use of mycelium as a sustainable construction material. They have studied the structural properties of mycelium and developed techniques for growing mycelium-based panels suitable for architectural applications.
Coined biodesign and biotechniques, the mycelium industry has far-reaching potential across more and more sectors.
Along with the industries cited above, mycelium is being in products in the grocery aisles as well. Plant-based ‘meat’ is not new: Impossible Burger, Beyond Meat and others are pioneering the segment. From health, to the rise in the world population growth, climate change, constraints on natural resources and animal welfare, groups around the world are looking at mycelium as a potential solution.
Mycelium-leaders Ecovative entered the market in September 2019 with Atlas Food Co., dedicated to the future of animal-free meat. The company’s CEO Eben Bayer told Forbes that from dense like steak to crispy like bacon, “mycelium po-

tentially has the right structure to be used as a scaffolding for a variety of plant-based meats.” Atlas will partner with food companies and develop the best structures to replicate the texture and feel of whole cuts of meat such as steak and chicken, versus the ground product on the market today. Talk about feeding a trend within a trend.



American Mushroom, headquartered in Avondale, is a national voluntary trade association representing the growers, processors, and marketers of cultivated mushrooms across the United States and industry suppliers worldwide. For more information, visit www.americanmushroom.org.

Charles Brosius, the grandson of a mushroom grower with the same name, had his eyes focused on a future as a professional engineer during his years as a Unionville High School student.
As time went by, however, the events he encountered during his life balked at his aspirations so heavily that he followed a path into farming and became a legend not just in the local agricultural community, but in the entire state of Pennsylvania.
Brosius, 93, said that, in the 1940s, while he was one of 42 members of the school’s class of 1948, the society around

them was changing. People were moving into the area to work for companies like DuPont in Wilmington, and they had desires for their kids to go on to college and pursue their own prosperous lives through a good education.
Although he was a member of a farm family, Brosius eschewed the agriculture curriculum at the school and stuck with college prep courses. At that time, there was a segment of the male students who were engaged in the Ag science curriculum, while many of the girls took the secretarial course.
Brosius said he had his eye on a professional future as an engineer because he was fairly handy with tools and technical instruments, and the professional life had its benefits—like a good paycheck, weekends off and two weeks of vacation during the year.
Farmers don’t have that luxury, he said, because the crops arrive every day, even on the holidays or weekends.
He said he told himself as he engaged in the college life at Millersville State College, “If I never walk inside a mushroom house again in m life, it will be too soon.”
The academic life was difficult for Brosius, however, because he found it hard to compete with the urban classmates who had a leg up on the ins and outs of education.
And yet, this difficulty was the beginning of his road back to the heights of agriculture that would take Brosius to the West Marlborough Board of Supervisors, the rank of Master Farmer, the Pennsylvania Secretary of Agriculture and trusteeship of Penn State, among other positions.
Early on, he took on menial jobs – even kitchen dishwashing -- to help pay his way for college. Almost as a foreshadowing of his future, he would somehow connect with higher positions each time that provided him with a few more dollars here and there.
Even as he worked in his menial kitchen job, an associate told him of a position cleaning out calf stalls on weekends that would almost double what he was making.
Brosius said he took that job for the financial benefits on weekends, even as his friends were going off to see football games. But part way through that calf job, he inadvertently reconnected a milking machine to the utters of a cow that had tipped over a bucket of milk.
That action didn’t go unnoticed by his superiors, who concluded this man was a farmer.
Additionally, early on in his pursuit of an education for engineering, he was told by a college dean, “What else do you want to do ‘cuz you’re going to fail engineering.”
He went on to major in dairy science at Penn State, and later took over the management of his father’s farm. The transition from a dairy operation to mushrooms came, he said, because the winters were ideal conditions for growing and it was a profitable thing to do in a season when the duties of running the dairy herd was lessened.

Brosius shows himself to be characteristically an individual who faces adversity and opportunities head on. While he said, “I’m the luckiest guy,” the truth is that the events of past history -- if they could talk -- have been lucky to encounter him.
Continued on Page 40
Continued from Page 39
Throughout his life he appeared to embrace whatever situations fate threw at him.
During the attack on mushroom growing industrywide by a disease referred to as “X-Disease,” a friend suggested that the cause might be somehow related to something in the air. Even though his investment in the mushroom-growing had been cut by lack of production, he borrowed money to design and build an air handling/filtering machine. He installed it in one mushroom house and left the other unprotected. Shortly afterward, the house with the machine produced mushrooms and the unprotected house did not.
Another time, the company that purchased and distributed his fresh mushrooms in New York City informed him that the weight of his mushrooms he declared was inaccurately high. He found out that the containers in which he had packed them were porous and had absorbed moisture – and thus weight – from the contents.

He developed a blue plastic container that was not only attractive but waterproof. The moisture weight stayed in the mushrooms.
To this day he retains the rights to the blue, plastic containers.


Pennsylvania Governor Tom Ridge, who was elected in 1994, tapped Brosius for state Secretary of Agriculture. That was a high point in his career and his life.
But there have been challenges, too.

This past February, fate threw another challenge at Brosius. The garage on his home property caught fire and destroyed many of his antique cars as well as his beloved calliope (or “band organ”) that sat on one of his old Fords.

In recent years he has found joy in showing up at local events and playing the merry-go-round music for visitors as well as driving his old cars in parades.

Watching the remains after the fire, he said, “I cried for three days.”



However, as he has in the past, he shortly began to rebuild the garage and find a replacement for the calliope.
His search for a new calliope has taken him nationwide to find the machine, a person willing to sell one, and a roll of merry-go-round music to install. He has also engaged in investigating speakers to increase the sound. He has been successful, and he believes the vehicle and the calliope will be fully ready for showing off soon.
In recent months, Charles and his wife, Jane, have moved
to Jenner’s Pond Retirement Community in Penn Township. They still retain ownership of the West Marlborough home, and he drives there each day to oversee the repairs, tend to the lawn and feed Molly, his dog.

Molly is also cared for by a tenant on the property.
The Brosius farm, Marlboro Mushrooms, is still in operation and is owned and managed by his two sons. It is run on renewable energy and has been honored as the oldest farm in Chester County.
Charles Brosius, whose great-grandfather tried growing mushrooms in a converted chicken coop and pig barn on an apparent whim, remains a legend in Chester County. He still treads those rural grounds daily and delights in trimming the grass on his new lawn tractor and fine-tuning his new calliope.


Continued from Page 43
*All events are tentative. check the website: Mushroomfestival.org for up-to-date information
Saturday, Sept. 9 and Sunday, Sept. 10
Note: Buses will run on Saturday until 6:30PM and Sunday till 4:30PM for offsite parking. If you re at a stop after this time the buses will no longer be running.

Street Fair
Over 200 vendors from all over the country will line the streets with arts, crafts, food and more. Local restaurants in the downtown area will prepare their mushroom specialty dishes. The Street Fair spans from Church Alley to Garfield Street.
Saturday, 10 AM to 6 PM
Sunday, 10 AM to 4 Pm
Mushroom Growers’ Exhibit
See mushrooms come to life from the tiny spore to the mature, ready to eat fungi! Walk your way through the mushroom growing exhibit, where you will see how white button, baby bella, portabella, hiitake, maitake, oyster, and royal trumpet mushrooms grow. 10 a.m. to 6 p.m and Sunday 10 a.m. to 6 p.m.
Located at the Corner of State Street and South Broad Street.
Everyone asks for Mushroom Soup when they attend the Mushroom Festival. The official Mushroom Soup of the Festival is a cream of mushroom soup made with local Kennett Square Mushrooms.
Painted Mushrooms
Mushroom Silent Auction
Artists become very creative with these 20 lb. toadstools – perfect for your garden or home. Cash prizes are awarded to the top three artists. Everyone can vote for their Festival Favorite -- the winning artist receives a cash prize,! Painted Mushrooms are displayed at State and Broad Streets. There is also a 108lb painted mushroom which you can purchase chances for $2.00 each or 3 chances for $5.00 painted by a local artist Jane Donahue Henry. Drawing will be at 3PM on Sunday and announced at the festival and on the website.
Saturday, 10 AM to 6 PM.
Last bid taken at 3 PM Sunday
Who do you think is the Cutest Button, Crimini and Portabella? Vote for your favorite contestant/photo with your pocket change in this baby photo contest on South Broad Street. All proceeds will be donated to a local charity.
Saturday, 10 AM to 5:30 PM
Sunday, 10 AM to 3:30 PM
Mushroom Sales
Many cultivated varieties of mushrooms can be purchased at the Mushroom Sales Booth on South Broad Street..A Refrigerated truck will hold your mushroom purchases fresh until you are ready to leave the Festival.
Saturday, 10 AM to 6 PM
Last pick-up is 6:15 PM
Sunday, 10 AM to 4 PM.
Last pick-up is at 4:15 PM
Children’s Entertainment
Great entertainment is scheduled on Saturday and Sunday for children of all ages.
Continued on Page 44
STARTING AT $21,495

Continued from Page 43
Happy Heart Clown ‘N Stuff will be twisting balloons in the parking lot at 300 W. State Street, Moon Bounce Bunge Jumping and Children’s games will be located starting at 300 West State Street
Saturday, Sept 9
Antique and Classic Car Show





Shady and spacious Broad Street, with its numerous examples of Victorian architecture, provides the backdrop to our Antique and Classic Car Show. South Broad Street from Cypress to Mulberry Streets, 10 a.m. to 4 p.m.
Fun Gus,
The Mushroom Festival’s mascot makes a few appearances during the Festival. Keep your eyes open for a red-capped mushroom strolling down the street
11:00AM Look for FUNGUS at South Union Street
2:00PM Look for Fungus near the Growers Tent on South Broad Street
5:00PM Look for FUNGUS by Letty’s Tavern
Culinary Events
The Culinary Tent, at the corner of South Union Street and Cypress Street, brings a wide range of chefs to Kennett Square to share their love of cooking with mushrooms. Guest chefs sharing their tips and recipes!
12:30PM Chefs: Kiki Aranita & Chadwick Boyd
2:00PM TBD
3:00 Chef Anthony Young From Hank’s Place
4:00PM TBD
Live in Kennett Square
Throughout the weekend there will be continuous live music for your listening pleasure at our music venue’s location in Liberty Place
Parking Lot near Center and State Street
11:15AM Jack Marshal
12:30PM Josh Komorowski
1:45PM Angelee




3:00PM Swamp Ash
4:15PM Tommy Froelich Band
CHOPPED Mushroom Cook-off - 10:00AM on South Union Street at the Culinary Tent
This year’s Amateur cook-off is going to be our version of a “Chopped” Challenge. The Chopped challenge is similar to the show you have seen on the Food Network. The Mushroom Festival‘s “Chopped” challenge is to combine all the foods in the mystery bag into a tasty and creative dish. The contestants must cook their dish in 30 minutes or less. They will need to complete 3 plates for the judges. Once time is up the judges will critique the dishes based on taste, presentation, creativity and the best use of mushrooms.
2:00 PM on South Broad in front of Anchor Fitness
Join us for the 2023 MUSHROOM PICKING CONTEST as 6
In Case of Severe Weather mushroomfestival.org
Pets: We love animals too, but... leave your pets at home. For the safety of your pet and others, pets are not allowed on the grounds of the Street Festival.
professional mushroom harvesters compete for BRAGGING RIGHTS as #1 Mushroom Harvester as they show off their FAST HANDS and KNIFE SKILLS!
Contestants will be judged on:

Speed

Mushroom Quality
Mushroom Size
2:00 PM Chef Kiki Arantis
3:00 PM Chef Anjel from The Naked Olive
Live in Kennett Square
Throughout the weekend there will be continuous live music for your listening pleasure at our music venue’s location in Liberty Place
Parking Lot near Center and State Street
11:15AM 3 O’Clock High
12:30PM Devin Canfield
1:45PM All the Living and the Dead
3:00PM Andrew Lipke and The Azrael String Quartet
Fried Mushroom Eating Contest 12:30PM on South Union Street at the Culinary Tent
Buona Food’s Original Fried mushrooms are a Festival favorite every year! But only a few have the opportunity to eat copious amounts of the crunchy, mouth watering snacks during the National Fried Mushroom Eating Contest. To beat the World Record, a contestant will have to eat more than 11.5 pounds of fried mushrooms in just 8 minutes! The local amateur record was set at 4 pounds. Join us in the Special Events Tent to watch the spectacle and cheer on the amateur only contestants as they challenge the 4 -pound World Record!
CHOPPED Mushroom Cook-off - 10:00AM on South Union Street at the Culinary Tent
This year’s Amateur cook-off is going to be our version of a “Chopped” Challenge. The Chopped challenge is similar to the show you have seen on the Food Network. The Mushroom Festival‘s “Chopped” challenge is to combine all the foods in the mystery bag into a tasty and creative dish.
The contestants must cook their dish in 30 minutes or less. They will need to complete 3 plates for the judges. Once time is up the judges will critique the dishes based on taste, presentation, creativity and the best use of mushrooms.
Meet Fun Gus
FESTIVAL ADMISSION $5

Everyone 12 and older is required to purchase a
This year, the Mushroom Festival awarded $77,000
The Mushroom Festival’s mascot makes a few appearances during the Festival. Keep your eyes open for a red-capped mushroom strolling down the street
11:00AM Look for FUNGUS at the Grower’s Tent
1:00PM Look for FUNGUS at South Union Street
3:00PM Look for FUNGUS’s Last appearance at the 2023 MUSHROOM FEST Strolling the Festival
Picking Contest 2:00 PM on South Broad Street in front of Anchor Fitness
Join us for the 2023 MUSHROOM PICKING CONTEST as 6 professional mushroom harvesters compete for BRAGGING RIGHTS as #1 Mushroom Harvester as they show off their FAST HANDS and KNIFE SKILLS!
Contestants will be judged on:
Speed

Mushroom Quality
Mushroom Size



 ALL-NEW 2024 CHEVROLET BLAZER EV
ALL-NEW 2024 CHEVROLET SILVERADO EV
ALL-NEW 2024 CHEVROLET EQUINOX EV
ALL-NEW 2024 CHEVROLET BLAZER EV
ALL-NEW 2024 CHEVROLET SILVERADO EV
ALL-NEW 2024 CHEVROLET EQUINOX EV
STREET FESTIVAL VENDORS
E63
B39,
Business name
Power Home Remodeling
Painted Sky Alpaca Farm LLC
Kennett Brewing Company
Silver City Mugs
South Mill Champs
The Woodlands at Phillips Mushroom Farms
Letty’s Tavern
Schweiger Dermatology
Mrs Robinson’s Tea Shop
Gosia’s Pierogies
Trattoria la tavola
Top Dog Concession
Marche
Currie Hair, Skin Nails
Square Pear Fine Art Gallery
Good Time Health
Sheridan Lawyers
Sherri’s Crab Cakes
Susan Bradfield DBA
Papa’s Kettle Korn
Buona Foods Inc
Passanante’s Home Food Services
La Verona Restaurant
Many Hands Coffee Co.
Spiderbite Boutique
Dough Sweet
GreenRoots Landscaping
Fusco’s Water Ice
Portabellos of Kennett Square
Wow Fudge and Belgian Chocolates
Sweet Amelia’s Green Eyed Lady
Maura Grace Boutique
Big E’s LLC
Sophisticated Bling Studio
Talula’s Table
Clean Slate Goods
Mushrooms Way
Lily Asian Cuisine
Me & My Dog Pet Bakery, LLC
Abi Toads
Fab and Boujee Boutique
Element on State
Kennett Collaborative
Nottingham Bonsai
Jersey Mikes
Booths D24 D25 D28 D29 D30 D31 D32 D33 D36 D37 D38 D39 D40 D41 D44 D45 D47 D48 D49, D51 D50, D52 D53 D54 D55 D56 D57 D58 D60 D61 D63 D64 D65 D67 E01 E02A E03 E04 E05 E06 E07 E08 E09, E11 E10 E101 E103 E105 E107 E111 E117 E12 E15 E16 E17 E18 E19
Cigar Life
Chantilly Blue LLC
Nordic Dreams
LuCass Boutique
Terraintextures
Kennett Square jewelers
TRAIL CREEK OUTFITTERS
Goodway Gourmet Bakery
Boothwyn Pharmacy
Nectar of the Vine
Sou-Pasta (Pappardelle’s)
Tri-State Senior Insurance
The Growing Tree
Stone Spring Suri Farm LLC
Carol’s Custom Birdhouses
The Comfort Station
Makinit Desins By Vicki
The Southern Beekeeper
Whiskey Hollow
Stori Gems
Pet Bandanas USA
Seader Design Co
I See Spain
Nomadic Pies
Hemlock Hollow Enterprise
NRG
Iris Gardens
J&J Kettle Korn, LLC
Heiler Painting
Charmed by Myrna Shroomy Stitches
ChristianaCare
VEGKY Mushroom Jerky
MTnest Woodworks Hip Klips Mini Purse TorchBearer Sauces
Habby Fruit Hot Sauces Honorable Oak All About
Caitelle
Willow Street Pictures
Astro Vinyl Art
Crafts 101
F+V Design Studio
Worx Essentials CBD
Rockys Hot Sauce
Nica-Art
Scentsy
Amber & Christmas Ornaments
Burning branch studio
TieBro handmade Bow Ties
Earth Products Essentials LLC
Monster Bows & Access LLC
Three Tuxedos Pottery Studio
T.O’s Hot Spice
Calabrese Arts Co.
Forager’s Kingdom
Skyseed Energy
Ryan Messner Glass Art
Pretty Petals Style:
LuLaRoe Juliann Manley
Tastefully Simple
FIVEG
Tupperware
Hen and Chic Vintage
True Honey Teas
Cosmic Opal’s Wellness
Hank sauce
Gourmet Gifts Inc
Renewal by Andersen
Taylor Chip
Zerep,Llc
Center Court Productions, Inc.
SkylineCottonCandy
Rita’s of Kennett Square
Sew Much Cooler
Soco Swings
Lion’s Grove Farm
Cafe Gourmino
Paiya
Losco Glass
Sherwin Williams
Applebee’s Neighborhood Grill + Bar
TwirlyandWags
Maisie Daisy Designs
Bath Bombs Baby
Butterfly House Soap Company
Terpy Holistics
Davey Tree
Elie Handbags
F17 F18 F19 F20 F21 F22 F23,
F27,
F26,
Hands-on Glass Studio
Edye’s Naturals
CrazyFaces FacePainting & Body Art
Whiz Spiegs Designs
RAVEbandz
Woodland Country Creations LLC
Greg’s Art & Garden Iron Revolution Bees
Luci’s Pet Pantry
Aether Artificers
Seth’s Custom Creations
the shabby chic garden
Better Half Artistic Designs
The Bay Gypsy
Lucky Bat Paper Co.
Color & Flame
Sew Many Roadz
Greta’s House
Claranda Tay Candles Co
Blazing Bella Balsamic & Olive Oil
Hope’s Caramels
Joy Love Handmande
KC Essentials
Goss Paints
Hammer & Needle Heirlooms
LoveLeigh Craft Co
Art by Blossoms
Kygokoi Illustrations
Cook Awesome Food
Calisma llc
Kimberlys krafts
Elizabeth Peyton Creations,llc
Stoney Treasures
Krapf School Bus
ACRE Windows & Doors
Green Star Exteriors
Five Star Home Foods
PathStone Corporation
leaf guard
Volpe Enterprises, Inc.
Qfix
TSI Home Improvements LLC
Pearly Whites
Children’s Dentistry
G. Fedale Roofing and Siding
KeyBank
Moyer Pest & Lawn
Kirkin Exteriors
With over 200 vendors you will surely find everything you are looking for. New this year is our G Block, showcasing many mushroom related items. Reference the map in the center spread for the exact locations.

bll ( hblh)
Por·ta·bel·la (pawr-tuh-bel-uh):
a mature, very large crimini mushroom, Agaricus bisporus. Portabellas are mature agaricus mushrooms where the veil has opened and the gills are exposed.
Royal Trumpet (roi-uhl truhm-pit):
has a trumpet-shaped tan cap and thick, white stem. Also called King Oyster, Pleurotus eryngii.
The Royal Trumpet mushroom is the largest species of the oyster mushroom.




Cri·mi·ni (kruh-mee-nee):



an edible, dark-brown mushroom with a rounded cap, Agaricus bisporus.
The crimini is an immature portabella, picked before the gills are exposed. It is known by many names including baby portabella, baby bella, Roman mushroom, Italian mushroom and brown mushroom.
Beech (beech):

crisp, firm fleshed fungi with short stems, Hypsizygus tessulatus.
In nature, the beech mushroom is found high up in the yokes of trees. It is cultivated on jars filled with corn cobs.
Oyster (oi-ster):
an edible fungus having an oyster-shaped cap, Pleurotus ostreatus.
The yellow oyster is described as delicate like a daffodil and could be used as a centerpiece.

Maitake (my-tah-key):

rippling, tan shaped mushroom without caps, also called Hen of the Woods, Grifola frondosa. In Japanese, “maitake” translates to dancing mushroom. In other parts of the world this mushroom that grows at the base of trees in the wild is called Hen-of-the-Woods, Ram’s Head and Sheep’s Head.
Pom Pom (pom-pom):
white sphere fungi with soft spines and no stem, Hericium erinaceus
Button (buht-n):


Btt(bht )
a usually small white mushroom in which the pileus has not yet expanded, Agaricus bisporus

Shiitake (shee-ee-tah-key):



a large, meaty, black or dark brown mushroom, Other common names are Golden Oak, Black Forest and Oakwood, Lentinus edodes.
As both food and medicine, the shiitake has been revered in Asia for thousands of years. It grows in the Far East on fallen broadleaf trees, include the “shii” tree in Japan.



Sodium is an essential nutrient. It works in the body to regulate blood pressure and maintain fluid balance. As critical a mineral as it is, excess sodium intake can increase blood pressure because it holds excess fluid in the body, putting extra strain on the heart and can contribute to increased incidence of heart disease and stroke.
The vast majority of Americans exceed the recommended limit for sodium in the diet. An average American has 3,400 milligrams (mg) each day, nearly 50 percent more than the amount recommended by the American Heart Association and the Dietary Guidelines for Americans. These and other public health organizations recommend limiting sodium in-

take to no more than 2,300 mg a day. The limit is set even lower for the 70 million Americans with high blood pressure or risk factors for high blood pressure (over age 51, African American, diabetes, chronic kidney disease). Those at risk should have no more than 1,500 mg a day.
According to Mushroom Council, excess sodium in the diet can add up very quickly. However, despite popular belief, the saltshaker is not the culprit. In fact, only about 11% of sodium intake comes from salt added to foods while cooking or at the table. Instead, the majority of sodium in the American diet comes from processed, packaged, and prepared foods, in addition to meals eaten away from home. This makes it difficult to control how much sodium is consumed.
Continued on Page 52

Mushrooms can be a great substitute for salt in dishes, offering various health benefits and adding a rich umami flavor to culinary creations.
Umami is a taste sensation that is often described as savory, meaty, or brothy. It is recognized as the fifth basic taste, alongside sweet, salty, sour, and bitter. The term “umami” was coined by a Japanese chemist named Kikunae Ikeda in 1908 and is derived from the Japanese word meaning “deliciousness” or “pleasant savory taste.”
The history of umami dates back even further. Although the concept of umami was officially identified in the early 20th century, the taste itself has been appreciated and sought after in various cultures for centuries. The unique taste associated with umami can be found in many traditional dishes and ingredients from different parts of the world.
One of the earliest examples of umami-rich ingredients can be traced back to ancient Rome and its use of fermented fish sauces like garum. These sauces, made from fermented fish or shellfish, provided a strong savory taste that contributed to the overall flavor of Roman cuisine.
Today, mushrooms are renowned for their umami-rich properties. Varieties like shiitake, oyster, and porcini are particularly prized for their savory taste and are utilized in numerous dishes, including stir-fries, risottos, soups, and sauces.

Other umami-rich foods include:
Parmesan Cheese: Aged Parmesan cheese is highly prized for its intense umami flavor. Grated or shaved Parmesan
can be sprinkled over pasta, salads, or roasted vegetables to enhance their taste.
Soy Sauce: Soy sauce, a staple in many Asian cuisines, is a fermented product that provides a potent umami kick. It is commonly used in stir-fries, marinades, dipping sauces, and soups to add a savory dimension.
Fish Sauce: Fish sauce, prevalent in Southeast Asian cuisine, is made from fermented fish or shellfish. It is used as a seasoning to intensify umami flavors in dishes such as curries, noodle soups, and stir-fries.
Miso Paste: Miso, a traditional Japanese seasoning made from fermented soybeans, contributes a robust umami taste. It is often used to make miso soup, marinades, glazes, and dressings.
Anchovies: These small, oily fish are packed with umami. Anchovies, whether used in whole or paste form, are frequently employed to enhance the savory notes in pasta sauces, Caesar dressings, and Mediterranean dishes.
Fermented Foods: Fermented products such as kimchi, sauerkraut, and certain pickles possess umami flavors resulting from the fermentation process. They can be enjoyed as condiments, side dishes, or ingredients in various recipes.
Continued on Page 54

Continued from Page 52
How can you incorporate mushrooms into your dishes?
Soups and Stocks: When preparing soups, broths, or stocks, mushrooms can be used to impart depth and enhance the umami taste. Adding sliced or diced mushrooms to simmering liquids will release their flavors and create a robust base without relying on excessive salt.

Sauces and Gravies: Mushrooms can be sautéed or finely chopped and added to sauces and gravies to provide a savory punch. They contribute a natural richness that reduces the need for added salt in these preparations.
Seasoning Blends: Dried mushrooms can be ground into a fine powder and used as a seasoning in spice blends. Mixing mushroom powder with herbs and spices can elevate the overall taste profile, making it a healthier alternative to salt-based seasonings.
Stir-fries and Sautéed Dishes: Incorporating mushrooms, such as shiitake, oyster, or portobello, into stir fries and sautéed dishes can bring a delightful umami flavor. The mushrooms’ natural savoriness enhances the overall taste, allowing you to reduce the amount of salt typically used in these dishes.
American Mushroom, headquartered in Avondale, is a national voluntary trade association representing the growers, processors, and marketers of cultivated mushrooms across the United States and industry suppliers worldwide. For more information, visit www.americanmushroom.org.


The Mushroom Festival is celebrating its 38th anniversary in Kennett Square in 2023 so to commemorate the special occasion, here is a list of 38 interesting facts about mushrooms.
1 Mushrooms have been eaten for thousands of years and can grow almost anywhere.
2 J.B. Swayne is credited with starting mushroom growing in the United States. Swayne started to cultivate mushrooms in Kennett Square which is, of course, the Mushroom Capital of the World.
3 Early Romans referred to mushrooms as the “food of the gods.”

4 Mushrooms love the dark. They thrive on it.
5 Mushroom production has becoming increasingly high-tech, with more and more computers being used to monitor production at each step.
6 A mycophile is someone whose hobby is to hunt edible wild mushrooms.
7 One portabella mushroom has more potassium than a banana.
8 Mushrooms are the fruiting bodies of certain fungi—the equivalent of the apple, not the tree. Fungi, including those which produce mushrooms, are not plants. They are related to molds, mildews, rusts, and yeasts, and are classified in the Fungi Kingdom.
9 There are over 38,000 varieties of mushrooms available, over 3,000 in North America alone, with varying colors, textures, and flavors. There are so many varieties of mushrooms, both edible and toxic, that mass consumption is pretty much limited to those commercially grown varieties which can be trusted to be edible.
10 In ancient Egypt, only Pharaohs were allowed to eat mushrooms because it was believed that the mushrooms appeared magically overnight. It was speculated at that time that lightning may have created the mushrooms.
11 According to the United States Department of Agriculture, the average American eats about four pounds of mushrooms every year.
12 The first recorded effort to cultivate mushrooms occurred around 1700 in France.
13 Mushrooms are useful not only as food and medicine—there are new uses being discovered all the time. Some mushroom varieties are being used in bioremediation to absorb and digest substances like oil, pesticides and industrial waste in places where these substances threaten the environment.
14 In 1990, the Mushroom Promotion, Research and Consumer Information Act was passed
by the U.S. Congress to strengthen the mushroom industry’s position in the marketplace, maintain and expand existing markets and uses for mushrooms, and develop new markets and uses for mushrooms. In 1993, the Mushroom Council was established to achieve the goals of this act.
15 Almost any mushroom except for the regular white mushroom is considered to be an exotic mushroom.
16 Mushrooms can grow very fast. As a consequence, the term “mushrooming” has become a popular word that can be attached to almost anything that grows quickly.
17 Mushrooms are a fungus and, unlike plants, they do not require sunlight to make energy for themselves.
18 Penicillin and streptomycin are examples of potent antibiotics derived from fungi.
19 Mushrooms are a superfood. They are the only food in the produce section of the local grocery store that produce Vitamin D.
20 Mushrooms contain disease-fighting properties, antioxidants, and a wide variety of important nutrients.
21 Portabella mushrooms, which are known for their meat-like texture and flavor, can reach a size of six inches in diameter.
22 Mushrooms contain more protein than most vegetables.
23 American Mushroom is headquartered in Avondale and works to promote mushrooms.
24 Mushrooms are comprised of 85 percent to 95 percent water.
25 Traditional Chinese medicine has utilized the medicinal properties of mushrooms for centuries.
26 Mushrooms are one of the most difficult commodities to grow. It is very labor-intensive to produce a consistent, high-quality crop.
27 Fresh mushrooms don’t freeze well. If it is necessary to freeze them, first saute them with butter or oil in a non-stick pan. Then cool slightly before freezing them in an airtight container.
28 Mushrooms rank the highest among vegetables for protein content.

29 Some of the oldest living mushroom colonies are fairy rings growing around the Stonehenge ruins in England.
30 Mushrooms are low in calories and contain no fat or sodium. Consequently, they are a very popular ingredient in salads.
31 In the Blue Mountains of Oregon is a colony of Armillaria solidipes that is believed to be the world’s largest known organism. The fungus is over 2,400 years old and covers an estimated 2,200 acres
32 Some mushroom spores can sit dormant for decades—or longer—and still grow if the conditions are right.
33 Mushrooms are available in fresh, dried, and in powder form.
34 Even the Bard, William Shakespeare, once waxed poetic about our favorite fungi, referring to “midnight mushrooms.”
35 Mushroom growing in the United States began after the Civil War and the growing seasons were very short at first. That has changed now, thanks to improved technology.
36 The stem of a mushroom is a good source of flavor and nutrients so there is no need to remove it. When you do need to remove the stem, chop it and add to stuffings, casseroles, soups and sauces.
37 New species of mushrooms are still being discovered each year.
38 Two-thirds of the white button mushrooms consumed the U.S. come from Pennsylvania mushroom farms. Pennsylvania farms produced 446.58 million pounds of white button mushrooms.
The story of how Oakshire Naturals became the world’s leading provider of Vitamin D2 mushroom powder is one told through lab experimentation, layers of approval and eventual worldwide distribution, but the proper and chronological tracking of the product known as EARTHLIGHT® began when curiosity and destiny collided when founder and CEO Gary Schroeder was a master’s student at Penn State in the late 1970s.
“My master’s research at Penn State was around the factors that affected the sizing of mushrooms,” Schroeder said from the company’s office in Avondale. “Why do some mushrooms grow small, some medium and some large, and how do we help to control that? There had been some work done in that area, but there were more open questions than answered questions.
“We learned a lot, and I was told 25 years later that my research was highly cited by others because we learned that the nature of what we do is foundational.”
It was then, between 1978 and 1980, when Schroeder
– with degrees in plant science and plant pathology -- realized that he couldn’t just be a mushroom farmer; that within the confines of his chosen professional path, the mushroom growing industry held secrets and solutions that he felt destined to find.
“As an undergraduate, the entrepreneurial bug began to bite me, and a lot of that came from my experience in leadership training I learned from the Boy Scouts,” Schroeder said. “I thought, ‘I can become an entrepreneur,’ but the question became, ‘Where and what?’ What I was learning back then about the mushroom industry that significant technology was just starting to come out that would eventually change the entire character of growing mushrooms.”
After spending the next four years getting his start in the industry, Schroeder began Oakshire Mushrooms in 1985 on a 24-acre property near Kennett Square, and quickly became a pioneer in the growing and marketing of specialty mushrooms, and was the first in the U.S. to grow and market commercial-scale Portobello and Shiitake mushrooms.
The volume of Oakshire’s sales skyrocketed when it signed

a brand licensing fee with Dole that permitted Oakshire to place the Dole logo on its products.
In 2008, Schroeder became part of a national discussion of industry leaders charged with the task of determining future marketing strategies for the mushroom by identifying – and then selling – its nutritional identity.


“If we are asked to identify the nutritional value of bananas, most of would know the answer: potassium,” Schroeder said. “Even though Portobello mushrooms contain more potassium than bananas, the industry wasn’t telling that story. As it had been known, exposing mushrooms to sunlight creates Vitamin D.
“So we thought, ‘How do we leverage this together, because with a powerful national brand (Dole) and some marketing muscle, I thought we could roll something out that would be very significant.”
In that same year, research and development let Oakshire to become the first company in the U.S. to create and patent a commercial light treatment process for mushrooms. The result was both innovative and groundbreaking: Oakshire was now growing – and marketing -100 percent DV Vitamin D mushrooms, an achievement that earned the company recognition for innovation in manufacturing.
“I found myself attending a lot of awards ceremonies, but after we rolled out the new product, the consumers just yawned,” Schroeder said. “Maybe the industry wanted to make the vitamin content of mushrooms our new identity, but we were hearing from consumers that they were buying fresh mushrooms because they liked the taste and texture.”
Continued on Page 60
Continued from Page 59
According to the U.S. Food & Drug Administration (FDA), a three-ounce serving of mushroom provides 400 international units (IUs) of Vitamin D2, but to Schroeder, it wasn’t enough.

“I drew an equation on a marker board and showed it to a lab technician, and at first he didn’t get it, but eventually he did,” Schroeder said. “Through all of these iterations and experimentations, we began to see that with a single gram, we could get between 40,000 and 50,000 international units of Vitamin D2.”
While the marketing of the nutritional value of mushrooms continued to motor quietly along, another innovation was being introduced to the industry: providing Vitamin D2 dried mushroom powder in capsule form, as a nutritional supplement. By 2012, the concept first entered the marketplace. Oakshire Naturals, the natural products division of Oakshire, was founded in the same year.
“Within three weeks, the FDA called us and said, ‘Stop. We don’t know what you’re doing,’” Schroeder said. “They told us that from a regulatory standpoint, there was a large void in supplying this product to the public, but the FDA kept telling us, ‘We think this product is safe, but someone has to pay for the data and put all of this together.
“Oakshire said to the FDA that we were willing to pay for the research because we thought we had a product that was worthy of that investment.
“The FDA viewed us as a solution to the problem of how to fill this gap. They were very helpful, and each one of those regulators gave us guidance on how to navigate so many aspects of the project.”
Over the next several years, Schroeder and his colleagues met with FDA representatives in Washington, D.C. They spent endless hours in laboratories perfecting their product. They learned about the relegated world of dietary supplements. They wrote and rewrote formulas and examined possibilities. A number of their patents were awarded by U.S., Canada and Europe for the process.
After nearly one dozen years of exhaustive research and meetings, Oakshire Natural’s Vitamin D2 Mushroom Powder received approval of its Food Additive Petition from the FDA in 2019.
“On the day it was approved, I asked the FDA what the next steps were, and the lead scientist told me, ‘We’re done. The science is fine, and we’re just waiting on the legal team to sign off,’” Schroeder said. “I was stunned, absolutely stunned.”
After additional regulations were passed, the product was published in the U.S. Federal Register in July 2020. Today, EARTHLIGHT® is the premier source for sustainable, plantbased, whole-food Vitamin D2. It is found in well over 200 supplement products in several countries around the world, and is also included in food items such as breakfast cereals, grain products and pastas, milk and dairy products, soups and broths and yeast-leavened bread and pastries.
All of the mushrooms produced for EARTHLIGHT® are grown on organic mushroom farms in Avondale.
“If you were to speak to me when I was in college and tell me that by 2020, I would be producing a mushroom product that was distributed around the world, my reaction would have been, ‘Of course,’” Schroeder said. “Even back then, I was always thinking in terms of making a global and sustainable impact.
“It takes hundreds of gallons of water to make a single pound of almonds. Conversely, it takes the mushroom industry only 1.8 gallons of water to make a pound of mushrooms. We’re very efficient, and we’re using straw and leftover by-products, so the source for fresh mushrooms is ideal, and all we’re doing is introducing it to light.
“Ten years ago, there was no market for what we are now doing, but now that we are here, it creates larger possibilities.”
To learn more about Oakshire Naturals, visit www.oakshirenaturals.com.
To contact Staff Writer Richard L. Gaw, email rgaw@chestercounty.com.

WHITE BUTTON
Chevrolet
SRILX Products,IronLinx,Qnectus
Mushroom Farmers of Pennsylvania

PORTABELLA
Basciani Foods INC
Phillips Mushroom Farms LP
PA Preferred
Giorgio
Baccellieri Family Dentistry
Truist Bank
Bentley Truck Services, Inc
Pollock Music Lessons LLC
Laurel Valley Farms Inc
Hillendale Peat Moss
R.M. Crossan
DuVall Bus Company
Greenwood Mushrooms
Murray Securas
Bunzl Mid Atlantic
Needham’s Mushroom Farm’s Inc.
Italian American Citizens League of Kennett Square
Amycel Spawn Mate
Southmill Champs
Longwood Gardens
The Giant Company
Manfredi Cold Storage
New Garden Township
Kennett Township
OYSTER
Becker Locksmith Services, INC
LGB Properties
Heritage Concrete
Blittersdorf Towing & Salvage
Kennett Square Apartments
Belfore Property Restoration
Chester County Press
Sylvan
Fulton Bank
WSFS Bank
Hadley
M&T Bank
MAITAKE
Mattioni Plumbing, Heating & Cooling
Taylor Oil & Propane
R.L. Irwin Mushroom Co
Wolfe Supply & Services
Umbriet Wileczek & Associates, PC
Penn Township
The Tri-M Group LLC
Omnilift INC.
WAWA
East West Label Company, Inc
John R. Stinson & Sons Inc
Lambert Spawn
Poores Propane
TRUMPET
Longwood Veterinary Center
Griffonetti’s
Greico Funeral Home
Brian Hartle State Farm Insurance
Next Home LLC
LGB Properties
Kennett High School
McGovern Sanitation
Kennett Fire Company No.1
Santander Bank
Chatham Financial
Matt Fetick Real Estate team
Atlantic Tractor
Davis & Company PC
Bob’s Crane’s
Delaware Valley Concrete
TO-JO Mushrooms
Buona Foods
Bryan Blittersdorf Automotive
Anchor Fitness
Modern Mushroom Farm
Kuzo Funeral Home, Inc.
Kennett Glass
SECCRA
Yo Sign Guy
Giorgi Kitchens


















Flavor: mild; blends with anything.
Common preparations: raw, sauteed, fried, marinated
In a serving of 4-5 white buttons:
• 18 calories
• 0 grams of fat
• 3 grams of carbohydrates
• good source of the antioxidant selenium, the B vitamins
riboflavin, niacin and pantothenic acid; and copper
• Approx. 300 mg of potassium
• 2.8 mg of the antioxidant ergothioneine
• 15 IU of vitamin D
Shiitake
Flavor: rich and woodsy, meaty texture
Common preparations: best when cooked in stir-fry, pastas and soups. Can be marinated and grilled.
In a serving of 4-5 shiitake mushrooms:
• 41 calories • 0 grams of fat • 10 grams of carbohydrates
• good source of the antioxidant selenium, providing 26 percent of the Daily Value. • a great source of B vitamins riboflavin, niacin and pantothenic acid; and copper
Sources: A Consumers Guide to Specialty Mushrooms and The Mushroom Council (www.mushroominfo.org)
Flavor: deeper, earthier flavor than whites, great addition to beef, game and vegetable dishes
Common preparations: saute, broil, grill, microwave
In a serving of 4-5 crimini mushrooms:
• 23 calories
• 0 grams of fat • 4 grams of carbohydrates
• excellent source of the antioxidant selenium, the B vitamin riboflavin and copper • a good source of potassium, phosphorus and B vitamins niacin and pantothenic acid
• 4.9 mg of the antioxidant ergothioneine
Photos by Carla Lucas

Continued from Page 65
Flavor: very delicate.
Common preparations: sauteed or stir fried then used in pasta dishes, meat dishes, omelets and soups.
In a serving of 4-5 oyster mushrooms:

• 36 calories
• 0 grams of fat
• 5 grams of carbohydrates
• good source of B vitamins riboflavin, niacin and pantothenic acid; and copper.
• more than 2 grams of fiber, nearly 10 percent of the Daily Value.
• nearly 3 grams of protein, 6 percent of the Daily Value.
Flavor: deep, meat-like texture and flavor.
Common preparations: grilled, broiled, sauteed and roasted; can also be used as a meat substitute.
In one medium Portabella cap:
• 22 calories
• 0 grams of fat
• 4 grams of carbohydrates
• excellent source of the B vitamin riboflavin
• good source of the antioxidant selenium, potassium, phosphorus, the B vitamins niacin and pantothenic acid; and copper
• 4.3 mg of the antioxidant ergothioneine
Flavor: delicate, chewy texture
Common preparation: grilled or used in stir frys. The stems can be substituted for baby scallops.
Flavor: mild, sweet taste.
Common preparations: slice and saute in butter, oil, or broth; can be used as a substitute for lobster or veal.
Flavor: crisp with a mild nutty flavor. Common preparations: sliced or served whole in sautes. Soups, pasta dishes.
Flavor: distinctive aroma and a rich, woodsy taste
Common preparations: sauteed lightly in butter or oil. Use in egg dishes, pasta sauces, soups, stews, and any recipe calling for mushrooms for a richer taste.


In a serving of 4-5 maitake mushrooms:

• 31 calories
• 0 grams of fat
• 6 grams of carbohydrates
• good source of the antioxidant selenium; B vitamins riboflavin, niacin and pantothenic acid; and copper
• more than 2 grams of fiber
• more than 900 IU Vitamin D










































The Mushroom Festival is much more than a fun-filled event that attracts tens of thousands of visitors to Kennett Square each September.
Proceeds from the festival are used to fund grant awards to dozens of local organizations that serve the community.
Adult Literacy Program Kennett
Library
ALS Association Greater Philadelphia Chapter
Arts Holding Hands and Hearts
Avondale Fire Company
Boy Scouts of America
Camp dream Catcher
Canine Partners for Life
Carasmark
Domestic Violence Center of Chester County
Family Promise of Southern Chester County
Friends Home
Friends of Anson B Nixon Park
Good Neighbors Home Repair
This year, the Mushroom Festival’s Board of Directors announced that it had received 63 grant applications, and they were able to award more than $77,000 in grants to help support a wide variety of programs and initiatives.
These are the organizations and nonprofits that have received grant funding from the Mushroom Festival:
Good Samaritan Services
Hero Hunts Foundation
Housing Partnership of Chester County
Kennett After School Association
Kennett Area Food Cupbaord
Kennett Area Senior Center
Kennett Collabrotative Memorial Day Parade
Kennett Fire Company NO.1
Kennett Heritage Center
Kennett Underground Rail Road
LCH Health and Community Service
Longwood Fire Company
Meals on Wheels of Chester County
Mighty Writers
New London Counseling Center
Opportunity Center/Handicrafters
Oxford Art Alliance
Prepared to Thrive
Reins of Life
Rotary of Kennett Square Light
Southern Chester County EMS
Spanish Health Ministry
Swayne, Campbell, Testa VFW post 5467
The Barn at Spring Brook Farm
The Garage Community and Youth Center
Tick Tock Learning Center
Walk in Knowledge
Rotary of Kennett Square Light





























As one of the top food festivals in the country, the Mushroom Festival makes for a fun-filled weekend and is certainly a good reason to visit historic Kennett Square. But a proper visit to enjoy all that the Brandywine Valley has to offer will take much more than a weekend.
Tourism is very important to Chester County and the entire Brandywine Valley, and there are plenty of fun activities to enjoy throughout the year.
The area is rich in history-- Revolutionary War buffs can enjoy a tour of the Brandywine Battlefield and the surrounding areas where U.S. history played out on Chester County ground. Outdoor beauty can be enjoyed at a number of parks and exquisite gardens, or on one of several top-rated golf courses. For those more interested in indoor activities, museums abound -- natural history, art and even helicopters are featured. Wineries are abundant, and offer tours, tastings and live entertainment throughout the year. For live theater, there are several community and professional theaters in the Chester County vicinity.
Why not extend your stay after the Mushroom Festival, or plan another trip to enjoy more of what we have to offer?
Here’s a quick look at some of the more popular attractions in Chester County.
1220 American Blvd., West Chester 610-436-9600, www.helicoptermuseum.org).
The American Helicopter Museum and Education Center is the nation’s premier aviation museum devoted exclusively to helicopters. They collect, restore and display historic aircraft and chronicle the origin and development of rotary wing aircraft. Fun for the whole family. Open to the public. Admission charged.
Route 1 in Chadds Ford 610-388-2700, www.brandywinerivermuseum.org.
Internationally known for works by three generations of the Wyeth family and its collection of American illustration, still life and landscape painting. Open daily. Admission charged.
Route 1 Chadds Ford 610-459-3342, www.ushistory.org/brandywine.
The Battle of Brandywine on Sept. 11, 1777 was the largest single-day land battle of the American Revolution. Tours include two historic houses: the Ring House, used by George Washington as his headquarters, and the Gilpin House.
632 Baltimore Pike, Chadds Ford (610-388-6221, www.chaddsford.com).
Tour the winery and enjoy special events. Visit website for information about upcoming events, locations of tasting rooms, and more.
Creek Road, one-quarter of a mile north of Route 1, Chadds Ford (610-388-7376, www.chaddsfordhistory.org).
Two early 18th-century house museums -- the John Chads House and the Barns-Brinton House -- are open for tours by costumed guides. The historic barn nearby hosts exhibitions about local history throughout the year. Admission charged.
225 N. High St., West Chester (610-692-4800, www.chestercohistorical.org).
Learn the stories of regional heritage through permanent and changing exhibits. Admission charged.
227 Bridge St. Phoenixville (610-917-1228, www.thecolonialtheatre.com).
The historic, single-screen movie house, known for its appearance in “The Blob” with Steve McQueen, shows art and independent films, as well as classic films and children’s films. There is also a schedule of live programs and concerts.
2301 Kentmere Parkway, Wilmington, Del. (302-571-9590, www.delart.org).
The museum’s collection focuses on American art and illustration, with permanent and changing exhibits. There’s an outdoor sculpture park, kids’ corner and café. Admission charged.
505 Market St., Wilmington, Del. (302-656-0637, www.dehistory.org).
Changing exhibits about Delaware history, as well as a permanent interactive exhibit that features 400 years of Delaware history. Admission charged. Call for hours of operation.
4840 Kennett Pike, Wilmington, Del. (302-658-9111, www.delmns.org).
Explore an African watering hole, marvel at a lifesized giant squid and dinosaurs, take the kids to a hands-on exploration area, and see a world-class collection of shells from around the world. Admission charged.
777 Delaware Park Blvd., Wilmington, Del. (800-41-SLOTS, www.delpark.com).
Racing, slots and golf are offered, with live thoroughbred racing from April through November. Open 24 hours a day, except for Sundays.
700 Folly Hill Road Kennett Square (www.galerestate.com, 484-899-8013).
Galer Estate Winery is a prestigious award winning boutique winery located just behind beautiful Longwood Gardens in Kennett Square. Offering wine tastings, wine sales, art shows and live music.
Route 141,Wilmington, Del. (302-658-2400, www.hagley.org).
Tour the historic buildings of the original du Pont powder mills, estate and gardens. The library collects, preserves and interprets the history of American enterprise. Admission charged.
20 Herr Dr., Nottingham (800-63-SNACK, www.herrs.com).
Take a free guided tour of this leading snack food manufacturer. Warm potato chip samples provided. Gift shop and café at the Visitor Center.
206 State St., Kennett Square (610-444-6363, www.kennettsymphony.org).
The professional community symphony offers concerts throughout the year. Visit online for an upcoming schedule of events.
Continued on Page 76
Continued from Page 75
Route 1, Kennett Square (610-388-2227, www.longwoodgardens.org).
Longwood offers 1,050 acres of woodlands, meadows, indoor and outdoor gardens, 11,000 types of plants, fountains, performing arts events, family activities, special exhibits and and classes. Admission charged.
114 W. State St., Kennett Square (610-444-8484, www.themushroomcap.com).
Fresh mushrooms from the family farm are shipped daily. Gifts and collectibles for sale. Open seven days a week.
Kennett Square’s most popular event (610-925-3373, www.mushroomfestival.org)
returns for the 38th annual festival on Sept. 9 and 10. There will be plenty of attractions, food, fun, and activities for people of all ages to enjoy.
150 Park Rd., Nottingham (610-932-2589).
The park covers more than one square mile and has one of the largest serpentine barrens on the East Coast. Located near the Pennsylvania/Maryland line, the park has pavilions and hiking trails.
Oxford’s downtown is charming and rich with history. The commercial district includes dining, an art gallery, and numerous unique shops. More information about the downtown attractions can be found at www.oxfordmainstreet.org.
In Landenberg (610-255-5684, www.paradocx.com), tour the winery and enjoy special events throughout the year.
Home to dealers who specialize in glass, silverware, furniture, rare books, vintage toys and more. Call 610-3881620 for more information.
124 Beaver Valley Rd., Chadds Ford (610-459-0808). Tour the winery and enjoy special events.
1200 Wilson Dr., West Chester (800-600-9900, www.qvctours.com).
A guided walking tour offers an informative look inside the world’s leading electronic retailer. Watch live broadcasts in action.
Stroud
970 Spencer Rd., Avondale (610-268-2153, www.stroudcenter.org).
A global leader in freshwater research and public education of watershed restoration. Located along the banks of the White Clay Creek.
8822 Gap Newport Pike, Route 41, Avondale (610-268-2702, www.valavineyards.com).
The winery specializes in small batches of very unusual blends made from rare Italian and French varieties, and delicious local artisan foods.
5105 Kennett Pike (Route 52) Winterthur, Del. (302-888-4600, www.winterthur.org).
Henry Francis du Pont’s 175-room mansion is furnished with elegant antiques, surrounded by 1,000 acres of grounds and gardens. Mansion and garden tram tours are offered, along with special exhibitions, and The Enchanted Woods for families. Admission charged.
50 Wyncote Dr., Oxford 610-932-8900, www.wyncote.com).
An award-winning golf course modeled after the great courses in Scotland.













Kennett Square restaurants make good use of their access to fresh, locally grown mushrooms by making them the star of the show in unique meals. From soup, to burgers, to flatbreads, and even breakfast items, mushrooms are embedded into the cuisine in the Mushroom Capital of the World.
Breakfast
Looking to start your day off with a savory, protein-packed meal that will keep hunger rumbles away until dinner? Omelets highlighting our fungi friend can be found throughout town. Hank’s Place at 201 Birch Street offers a Kennett Square Mushroom Omelette or Frittata, filled with a roasted mushroom blend, griddled onions and Swiss Cheese. Foxfire Restaurant at The Stone Barn, located at 100 Stone Barn Drive, features a Farmer’s Mushroom and Feta Omelet with sauteed exotic mushrooms, seasonal garden veggies and feta cheese. They also offer Shroom on a Single, a play on cream chipped beef, with creamed mushrooms

over sourdough toast with a sunny side up egg. For a quickstop, visit Mary Pat’s Provisions at Liberty Market Place (148 W. State Street), for their Mushroom Egg and Goat Cheese Sandwich topped with truffle aioli.
Handhelds satisfy both the comforting and daring foodies, and can easily be found on lunch and dinner menus. Look for any menu item with “Kennett Square” in the name, and mushrooms are guaranteed.
La Verona’s (114 E. State Street) ode to Kennett Square is their La Verona Burger with caramelized onions, mushrooms, American cheese, and a Kennett Square Sandwich with portobello, goat cheese, spinach, red onions and Hank’s

balsamic glaze. The Mushroom Gratin is a finer experience, made with smoked bacon, maitake, oyster and shiitake Mushrooms, blended with cheese and served with toast points.
The Naked Olive (759 W. Cypress Street) fancies the classic melt with their Kennett Square Mushroom Melt, with a blend of exotic mushrooms, baby spinach, sliced tomato, caramelized onions, goat cheese, balsamic glaze on a grilled sourdough bread.
Giordano’s (633 E. Cypress Street) has the widest selection of handhelds, featuring their rendition of the Kennett Square Burger, a Kennett Square Chicken Sandwich, and a Kennett Square Cheesesteak.

Craft breweries have joined the mushroom fanfare too, providing both good food and good brews.
Kennett Square Creamery (401 Birch Street) resides in the previous site of the Eastern Condensed Milk company, and has a sprawling venue for meals, community and rentals. Their extensive drink menu will quench the tastes for IPAs, hard seltzers and kombucha, wine and cocktails. For specialty mushroom dishes, try the Kennett Mushroom Flatbread made with Kennett portobello mushrooms, house tomato sauce, micro arugula and provolone. The Kennett Mushroom Burger checks the boozy bug with kennett portobello mushrooms, ale braised onions and swiss cheese.
Victory Brewing Company (650 W. Cypress Street) serves their beers and cocktails brewed all over Chester County, which pairs perfectly to their KSQ Burger topped with shaved onions and bacon aioli. Their spin on grilled cheese ramps up taste, with braised mushrooms, sautéed greens, mozzarella and hot cherry peppers. Looking to share? Try their Wild Mushroom Arancini, a fried rice ball stuffed with mushrooms and served with their Brotherly Love brew-infused marinara sauce.
Braeloch Brewing (225 Birch Street) offers another chance at a burger rendition with their Kennett Burger, topped with mushroom duxelles, Swiss cheese and caramelized onions. Try their Mushroom Duxelles Flatbread for something lighter, topped with roasted garlic, Monterey Jack and chives.
Vegetarian
Mushrooms make the perfect filler for vegetarian dishes, and these menu items are sure to satisfy any dietary choice or restrictions for diners.
Talula’s Table (102 W. State Street) sells their Vegetarian Kennett Mushroom Soup to go by the pint, but if you’d like to stay and eat in their cozy shop, they will warm it for you on the stove.

Continued from Page 79
Giordano’s Veggie Calzone is a classic take on the comfort food, stuffed with Broccoli, tomato, mushrooms, spinach, ricotta and mozzarella cheese
Victory Brewing Company’s It’s a Wrap fills a toasted tortilla with crispy cauliflower and mushrooms, cucumber, cabbage, carrots, pickled onions, scallions.
Sovana Bistro’s vegetarian Mushroom Ravioli dresses up the classic pasta dish with grilled portobello butter and aged goat romano cheese for a decadent, and delightful dish.
On the run and need some fuel? Try a quick-stop option from Liberty Market Place (148 W. State Street), a cafeteria style eatery for dine-in or take-out.
Mary Pat’s Provisions, open for breakfast and lunch until 3pm, has a Mushroom Panini grilled with roasted shiitake and cremini mushrooms, arugula, truffle aioli, and Swiss cheese on a multigrain bread.

State Street Pizza has a shareable Breaded Mushroom appetizer, deep fried and served with a size of marinara sauce. Besides pizza, they also have a Mushroom and Pepper Jack Burger, and a Mushroom Cheesesteak, highlighting the star of the show on classic handhelds.
From pasta to marsala, flatbreads and of course, soup, Kennett Square’s fine dining options make it easy to create a special night out on the town and indulge in some of the finest mushroom dishes anywhere.
La Verona’s Marsala offers a choice of Veal of Chicken, with marsala wine, mushrooms sauce, and mashed potato and vegetables as a side. Their decadent Risotto is made with porcini, portobello, cremini and black truffle mushrooms, parmesan, sun-dried tomato, and drizzled with truffle oil.
The Naked Olive’s Mushroom Velour Soup starter is a Greek take on mushroom bisque. Follow it up with their Kennett Pizza topped with mushrooms and truffle oil, or their Cavatapi A La Tartufa Pasta with creamy black truffle sauce and black tiger shrimp.

Letty’s Tavern ( 201 E. State Street) takes their own spin and spice on mushroom soup with mushroom broth, portobello, cremini, and shiitake mushrooms, chives and chili oil. Choose your mushroom-themed entrée from either their Cavatelli pasta is made with mushroom ragu and ricotta, or Mushroom Pizza made with fontina, mushroom duxelles and pan seared mushrooms.
JI In Eatery, a Korean food stand in the Marketplace, offers mushrooms mixed in with their Bibimbaps in various styles including Bulgogi, Jeyuk Bokkum, Teriyaki Chicken. A Bibimbap is a mixed bowl with sautéed vegetables (carrots, spinach, pickled diakon, shiitaki mushroom, soybean sprout, zucchini) over white rice topped with a fried egg. JI In Eatery meals come with a side of miso soup & gochujang (chili garlic paste).
Foxfire Restaurant at The Stone Barn has a staple Kennett Mushroom Chowder on their menu, plus a Kennett Swiss Burger featuring exotic mushrooms and a honey truffle mustard, and a Kennett Square Flatbread with marinara sauce, exotic mushrooms and mozzarella cheese topped with lemon truffle arugula and balsamic glaze.
For a seaside take on mushroom soup, try Catherine’s Restaurant (1701 W Doe Run Road) Wild Mushroom and Lump Crab Soup.









The 38th annual Mushroom Festival will grace the hamlet of Kennett Square and sprawl along State Street on September 9 and 10, and as a contributing writer for the Chester County Press whose editorial focus is heavily weighted on arts and entertainment, I was tasked with developing a guide for out-of-towners on where to eat while in town. At some point, you’re going to get tired of mushroom bisque, so what else is there?
While State Street holds the attention of most of the established restaurants in Kennett Square, perhaps you want to get a little off the grid. Maybe you want to experience something a little less curated.
If so, read on.
On a surprisingly mild Saturday in July, I ventured out to a couple of spots outside of my usual rotation for the express purpose of experiencing something new among the familiar. I’m not a foodie, and I am not looking for the perfect flakey crust or the newest spot with the freshest iteration of a balsamic drizzle. No, I wanted something that was good, that was local, and indicative of the varied facets of a community with a unique blend of deep cultural influences tied directly to agricultural roots.
I began my culinary journey at a food truck. I chose El Poblano II, situated in the gas station parking lot of Star Gas Station at 700 Cypress Road. I’ve driven by it many times, watching the smoke from the grill billowing across my car windshield as I pass by, but today, I stopped to place an order of grilled chicken with spicy barbeque sauce.
As I was ordering, an older gentleman in a convertible rolled up with half a cigar in his mouth and asked if there were any sausages today. I felt like he was an omen of good things to come.
I watched my chicken sizzle on the grill. The sole operator of the stand, a young man in a blue apron, placed it into a takeaway container with rice and my sauce. I was ready. There were other options, and visuals as displayed on a banner in front of the grill. I took my order and headed to my second location.




The next stop on my “been meaning to check it out” list was Guadalajara Express, at 520 South Union Street, located in a small Hispanic shopping center across from the Kennett High School that also offers a grocery store and a bakery. Unlike the previous joint, this restaurant is dine-in, with an option to take out.
Like many of the smaller Mexican restaurants in the area, Guadalajara also doubles as a butcher shop.
I entered at 4 p.m., usually a slow time for restaurants, but this place had a gathering at every booth. I walked up to an order window and was greeted by a friendly face on the other side. I ordered tacos Al Pastor and chorizo tacos, with salsa verde on the side. While waiting for the order, I posted up at a small bar stool area to the right of the window while a tela-novela played on a TV to no one in the corner of the restaurant.
After ten minutes, my to-go order was brought to me at the bar, and I made my way to my final destination, Anson B Nixon Park for a veritable feast.
If you want to escape the chaos of State Street this Mushroom Festival, I highly recommend a picnic in
Continued on Page 84
Geraldo Perez of El Poblano on Cypress Street. The “off-the-grid” feast was enjoyed at Anson B. Nixon Park.Continued from Page 83
the park and some solid Mexican food. Anson B. Nixon Park has been a staple of the community for years, and I’ve always enjoyed it for the diversity it welcomes. From pickleball, to birthday parties, a great playground where I take my daughter often, and the frisbee golf crowd, you get to see so many people enjoying their hobbies. As I unpacked my lunch on the picnic table, I was treated to a photo shoot of a quinceanera (a young lady in a billowing ball gown posed with five young men in matching pink shirts, cowboy hats and cowboy boots).
The food was great and plentiful -exactly what I’ve come to expect and appreciate about the authenticity of the local Mexican fare. I will say, the spicy BBQ sauce completed my grilled chicken, and the pillowy street-taco style of my al pastor and chorizo tacos hit the spot. While I’m a carnivor at heart, I would like to mention there are several vegetarian options at both of these locations.
You really can’t go wrong in this area when choosing a small local dive for tacos. As we celebrate the Mushroom Festival this year, let’s give a nod to the immigrant community that makes this all possible and imbues Kennett Square with a one-of-a-kind infusion of Hispanic influence.
If you’re looking for some other locations to try out that represent the entrepreneurship and culinary expertise of the Hispanic community consider the following:

Alondras Bakery, 113 West State Street
Baker Magnolia, 207 Magnolia Street
Cafe Evergreen
(I will count this as a bakery as they make their bread in house but this is also a fantastic Columbian cafe with a full menu and great coffee/smoothies/juices),
216 South Mill Road
Carniceria Camargo, 207 Magnolia Street
Deisy’s Cake Shop (excellent tres leches cake I order every year for my birthday), 315 West State Street
Mario’s Bakery, 520 South Union Street
Panaderia Lara, 625 East Cypress Street
Grocery Store
Hnos Lara, 710 West Baltimore Pike
Restaurants La Pena, 609 West Cypress Street
La Mixteca, 700 West Cypress Street

















